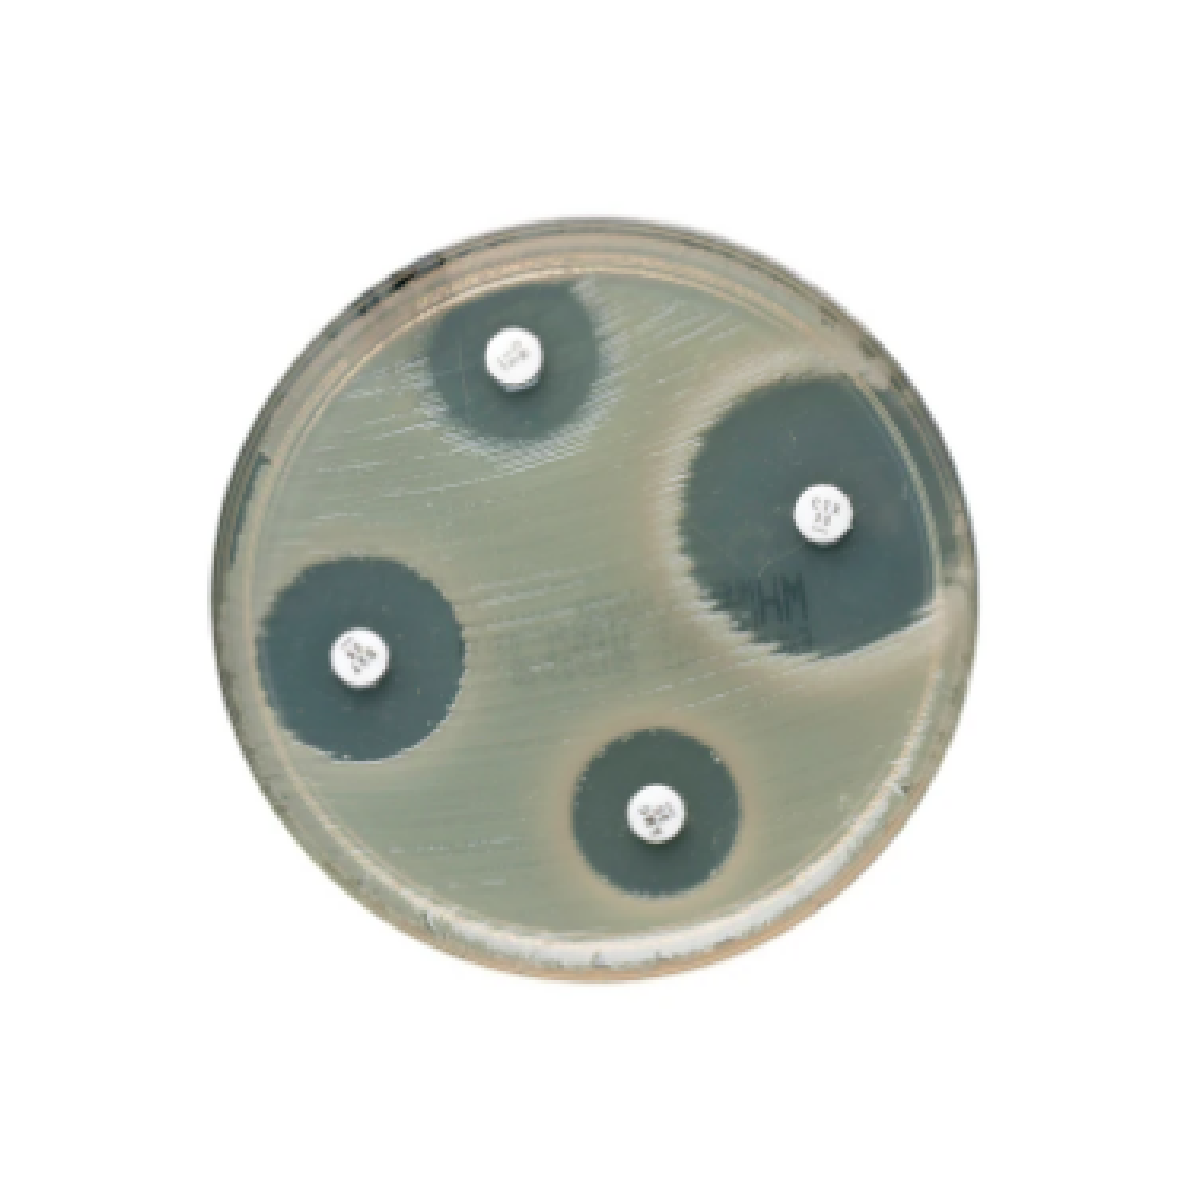
Oxoid™ Imipenem Antimicrobial Susceptibility discs / Discos de susceptibilidad antimicrobiana Oxoid™ Imipenem

Oxoid™ Imipenem Antimicrobial Susceptibility discs / Discos de susceptibilidad antimicrobiana Oxoid™ Imipenem
Determine manualmente la susceptibilidad a los antibióticos de los microorganismos mediante métodos de prueba de susceptibilidad a los antimicrobianos (AST) junto con discos de susceptibilidad a los antimicrobianos Thermo Scientific™ Oxoid™ Imipenem, confiables y fáciles de usar.